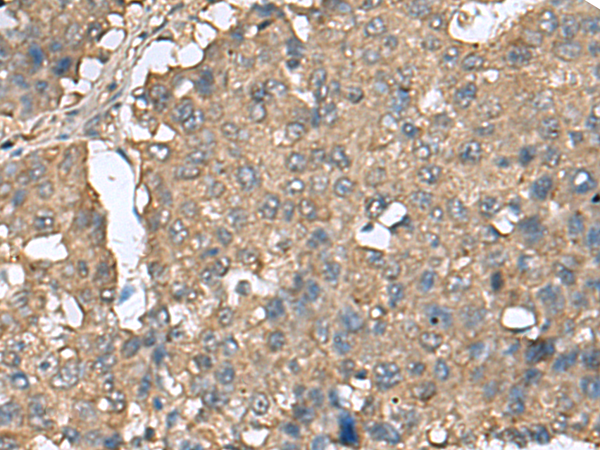

|
Background: |
ATP-dependent RNA helicase which is a subunit of the eIF4F complex involved in cap recognition and is required for mRNA binding to ribosome. In the current model of translation initiation, eIF4A unwinds RNA secondary structures in the 5'-UTR of mRNAs which is necessary to allow efficient binding of the small ribosomal subunit, and subsequent scanning for the initiator codon. |
|
Applications: |
ELISA, IHC |
|
Name of antibody: |
EIF4A2 |
|
Immunogen: |
Fusion protein of human EIF4A2 |
|
Full name: |
eukaryotic translation initiation factor 4A2 |
|
Synonyms: |
DDX2B; EIF4A; EIF4F; BM-010; eIF4A-II; eIF-4A-II |
|
SwissProt: |
Q14240 |
|
ELISA Recommended dilution: |
5000-10000 |
|
IHC positive control: |
Human liver cancer and Human esophagus cancer |
|
IHC Recommend dilution: |
50-200 |
購物車
幫助
021-54845833/15800441009
